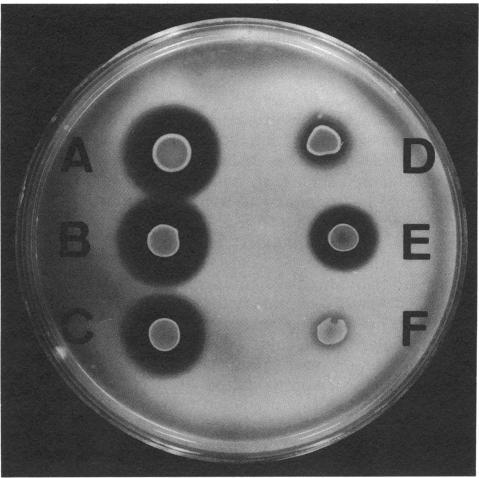

鳗弧菌毒力机制中涉及的一种金属蛋白酶基因的克隆
Cloning of a metalloprotease gene involved in the virulence mechanism of Vibrio anguillarum.
作者信息
Milton D L, Norqvist A, Wolf-Watz H
机构信息
Department of Cell and Molecular Biology, University of Umeå, Sweden.
出版信息
J Bacteriol. 1992 Nov;174(22):7235-44. doi: 10.1128/jb.174.22.7235-7244.1992.
Genetic evidence has previously suggested that a zinc metalloprotease is involved in the invasive mechanism of the fish pathogen Vibrio anguillarum NB10. In this study, the metalloprotease gene was cloned and sequenced. The sequence encodes a polypeptide (611 amino acids) that contains a putative signal sequence followed by a large leader sequence and the mature protein (44.6 kDa). Since the purified protein has a molecular mass of 36 kDa instead of the predicted 44.6 kDa, the mature protein is most likely processed a third time. Comparative analyses of the protein sequence showed high homologies to other bacterial metalloproteases within the zinc-binding and active-site regions. The Vibrio cholerae hemagglutinin/protease and the Pseudomonas aeruginosa elastase were exceptions in that the homology extended throughout the entire putative preproprotein. A chromosomal metalloprotease mutant was made via the integration of foreign DNA into the protease gene. This mutant did not secrete the metalloprotease, as determined by sodium dodecyl sulfate (SDS)-polyacrylamide protein analysis and by growth on gelatin agar. Transcomplementation of the chromosomal mutation revived the secretion of the metalloprotease and its activity on gelatin agar. Interestingly, when supernatant proteins were analyzed by gelatin-SDS-polyacrylamide electrophoresis, two different proteases (75 and 30 kDa) were detected in the mutant strain but not in the transcomplemented strain or the wild-type strain. Moreover, fish infection studies were done, and implications for the role of the metalloprotease in the virulence mechanism of V. anguillarum are discussed.
遗传证据此前表明,一种锌金属蛋白酶参与了鱼类病原菌鳗弧菌NB10的侵袭机制。在本研究中,克隆并测序了该金属蛋白酶基因。该序列编码一个多肽(611个氨基酸),其包含一个推定的信号序列,接着是一个大的前导序列和成熟蛋白(44.6 kDa)。由于纯化后的蛋白分子量为36 kDa而非预测的44.6 kDa,成熟蛋白很可能还经历了第三次加工。对该蛋白序列的比较分析表明,在锌结合区和活性位点区域,其与其他细菌金属蛋白酶具有高度同源性。霍乱弧菌血凝素/蛋白酶和铜绿假单胞菌弹性蛋白酶是例外,因为其同源性延伸至整个推定的前原蛋白。通过将外源DNA整合到蛋白酶基因中构建了一个染色体金属蛋白酶突变体。通过十二烷基硫酸钠(SDS)-聚丙烯酰胺蛋白分析以及在明胶琼脂上的生长情况确定,该突变体不分泌金属蛋白酶。对染色体突变进行反式互补可恢复金属蛋白酶的分泌及其在明胶琼脂上的活性。有趣的是,当通过明胶-SDS-聚丙烯酰胺电泳分析上清液蛋白时,在突变菌株中检测到了两种不同的蛋白酶(75和30 kDa),而在反式互补菌株或野生型菌株中未检测到。此外,进行了鱼类感染研究,并讨论了金属蛋白酶在鳗弧菌毒力机制中的作用。